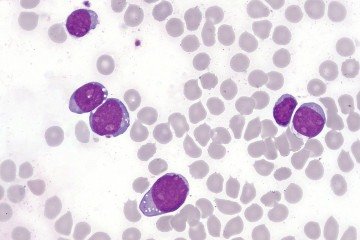
Células linfoblásticas T da leucemia aguda na medula óssea: poucas opções quando o tratamento principal falha - (crédito: WikimediaCommons/Divulgação ) Células linfoblásticas T da leucemia aguda na medula óssea: poucas opções quando o tratamento principal falha - (crédito: WikimediaCommons/Divulgação )

Crítica
O 'Divertidamente' de adultos: filme explora os filtros decisivos do amor

FIM DE ANO
Amigo oculto: o que pode e o que pega mal

Diversão e Arte
Jason Momoa surge em primeira foto como Blanka em ‘Street Fighter’

CINEMA
35 anos de Esqueceram de Mim: Onde está o elenco do filme?

Música
Caixa Cultural faz tributo a Naná Vasconcelos

Cinema

CAPITAL S/A
CB.PODER
BLOG PRIMEIRA INFÂNCIA
PARA DEPUTADOS
contra Fluminense
COLUNA BRASÍLIA-DF
COLUNA BRASÍLIA-DF
EIXO CAPITAL
Capital S/A
BLOG DA ROSANA HESSEL


















































































